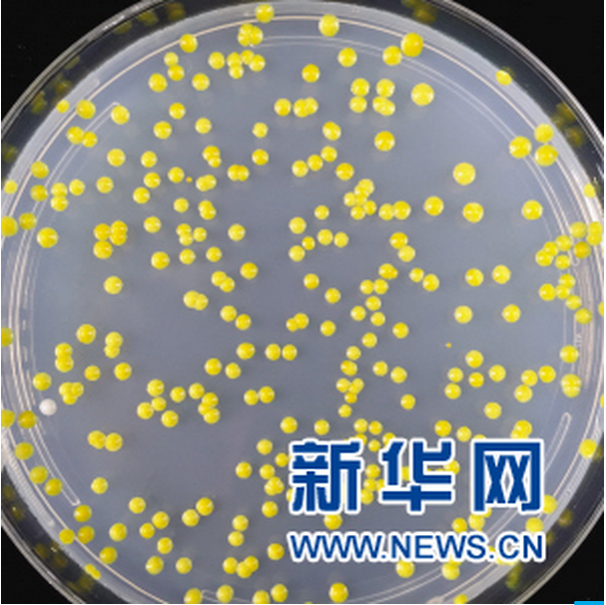

文/赵晖
巴黎时间10月26日,2024年国际遗传基因工程机器大赛(International Genetically Engineered Machine Competition, 以下简称“iGEM大赛”)全球总决赛在法国巴黎落下帷幕。本次大赛汇集了来自全球各地逾400支队伍,天津大学两支参赛团队获得2块金牌和1项单项奖提名的优秀成绩!
iGEM竞赛是合成生物学领域的国际顶级学术性竞赛,最早由美国麻省理工学院发起,是一项以合成生物学为核心,综合生命科学、数学、工程学、信息科学、艺术设计等多个学科的国际大赛,受到Nature、Science等学术期刊,以及 BBC 等媒体的广泛关注和专题报道。
天津大学是最早把这项国际赛事引入中国的高校。因为这项大学生国际比赛天津大学开设了一门本科生课程——基因组设计合成。缘起一项大学生国际比赛和一门本科生课程,经过十几年的发展,天津大学合成生物学从零起步走到世界科技前沿,站到了聚光灯下。

缘起:从一项国际赛事到一门本科金课
2006年,中科院院士、天津大学教授元英进了解到美国麻省理工学院发起的国际遗传工程机器大赛(以下简称iGEM)。这项比赛让学生们做一些标准化的基因元器件,然后组装起来实现塑料降解、砷污染检测等生物功能。元英进教授发现iGEM与天大合成生物课题组的新利18网址登录
理念不谋而合——运用工程学的方法来研究生物学,像造房子或者造汽车那样,先制作出砖瓦或者零件,然后再按照规则组装起来最终形成产品,实现功能。此外,在这个本科生的比赛过程中,通过头脑风暴式的交流讨论、自主学习、团队协作,提升学生能力和素养,这也正是天大想要的教学过程。于是,从这一年开始,天津大学组织学生开始参与这项赛事中。
2000年,人类基因组计划“工作框架图”完成,中国科学家按照国际人类基因组计划的部署,完成了1%。从那时起生物化工出身的元英进意识到,对生物的工程化研究将势不可挡。如果基因组测序是“读懂生命密码”,那么基因组合成就是在“编写生命密码”。在查阅大量国外论文,屡次拜访世界顶级大学实验室后,他把研究方向锁定在合成生物学上。
天津大学先是创立了一个合成生物学研究小组,组织学生备战大赛。从2007年起,天大化工学院开始指导学生团队正式参加iGEM大赛,还在2007年举办了国际合成生物学研讨会和TTT(Teach The Teachers)iGEM国际研讨会,引导更多高校了解这项国际赛事,参与这项国际赛事。

借助这项比赛,近二十年来,天大为合成生物学领域培养了大批优秀的青年人才。回溯历史,也正是这项赛事助推了中国乃至亚洲合成生物学的发展。
“大赛给了我合成生物学技术方向的启蒙,也为我未来的新利18网址登录
道路指引了方向。”美国加州大学圣地亚戈分校副教授李嫣然是首次出征iGEM大赛天大代表队的一员,目前致力于运用合成生物学的手段研究和改造植物天然产物的生物合成。
浙江天化科技发展有限公司投资总监潘清也是因为iGEM大赛,了解了合成生物学,合成生物成为了她重点关注的投资方向,“合成生物学已经从实验室逐渐过渡到了产业端,未来合成生物学一定会带来重大的生产方式的变革,解决人类能源、粮食、食品、环境、材料等诸多问题。未来10年,一定会涌现出更多的合成生物学公司,从底层的使能技术到生产应用型的企业,并且这之中一定会出来很多行业巨头”。
在iGEM比赛的基础上,天津大学还面向本科生开设了一门合成生物学课程--《基因组设计合成》。
像造房子或者造汽车那样,先“烧制”出砖头或者零件,然后再按照规则组装起来最终形成产品,运用工程学的一些方法来研究生物学,这是元英进在三十几年前就一直在考虑的问题。这门课教授学生构建人工合成染色体基础知识和技能。但这个看起来就像制作“砖头”的课程能够在培育学生发现和解决问题才能的同时,引导他们熟悉合成生物学领域的诸多前沿科学问题和最新进展。参加课程的学生们在为人工合成染色体“添砖加瓦”的过程中,也培养了科学精神、新利18网址登录
能力。

“大四毕业我没过暑假而是提前加入BAG课程。向师兄师姐学习实验技术,或者与同级的同学PK一番,在其乐融融的实验室氛围中,自己对酵母的分子生物学操作逐渐纯熟。我担任一个小组组长而且完成了最多的DNA材料的组装,这个小小的成绩也让我体会到了新利18网址登录
的乐趣和收获感。研究生正式开学之后,我们参与到了国际合作的酿酒酵母基因组计划(Sc2.0)中来,这个国际化的平台给予了我很多对新利18网址登录
的全新认知:新利18网址登录
不是那么‘老套’,新利18网址登录
也不是‘闭门造车’。Sc2.0计划让我一个刚刚毕业的本科生直接上了合成生物学前沿研究的快车。”当年的本科生吴毅,如今已经是天津大学教授,成长为中国合成生物学领域的青年才俊。

迭代:从一门本科金课到一项前沿研究
吴毅提到的酿酒酵母基因组计划(Sc2.0)是合成基因组学研究的旗舰项目——标志着人类开始向真核生物的合成进军。
原核生物的基因组相对简单,但动物、植物、酵母等真核生物具有多条线性染色体,生命形式更复杂丰富,通常会包含数亿甚至数十亿碱基对信息,所以合成一个真核生物的基因组是一项非常艰巨的任务。Sc2.0计划旨在重新设计并合成真核单细胞生物——酿酒酵母的全部16条染色体。
该项目由美国、中国、英国、法国、澳大利亚、新加坡等多国研究机构分工协作,致力于设计和化学再造完整的酿酒酵母基因组。Sc2.0计划带头人杰夫·伯克多次提到,是天津大学元英进教授的加入推动了这个项目的国际化。
《科学》封面文章刊登的是人类科学领域最前沿最重要的科学成果,北京时间2017年3月10日凌晨三点出版的国际顶级学术刊物《科学》,呈现的是科学家们在人工合成生命方面的进展。这次科学家们共完成了5条染色体的化学合成,其中中国科学家完成了4条,把Sc2.0计划向前推进了一大步。天津大学团队完成了5号和10号两条染色体的化学合成,并开发了高效的染色体缺陷靶点定位技术和精准修复技术;清华大学团队完成了12号染色体的合成;华大基因团队联合英国爱丁堡大学团队完成了2号染色体的合成。

根据学术界的署名习惯,论文的第一作者是创新性新利18网址登录
成果中贡献最大的直接执行者,通讯作者指新利18网址登录
成果的总体设计者和负责人。元英进此次在《科学》期刊上以通讯作者身份发表了2篇论文,而2篇论文的第一作者,分别是天津大学博士生90后的谢泽雄和1989年出生的吴毅,共同第一作者则是天津大学的80后教师李炳志。更让人惊喜的是,为这两篇文章做出酵母片段的数十名学生都列入了作者名单,许多人参与该项目时都是大二、大三的本科生。
2016年12月,在武汉工作的瞿蓝梦接到了师兄谢泽雄的电话,请他确认自己的新利18网址登录
内容并向《科学》提交他作为论文作者的个人资料。“太兴奋了,没想到我大三时合成的酵母菌片段,还有这么大用处。我也是发过《Science》的人了。”瞿蓝梦的惊喜溢于言表。
在Sc2.0计划中,元英进教授团队负责的5号染色体共有53.6万个碱基对,10号染色体则有超过70.7万个碱基对。要想通过化学方法从单核苷酸构建出完整的染色体是个庞大的工程。除了研究生,许多上过《基因组设计合成》课程的本科生们也加入进来,学生们在为合成人工染色体添砖加瓦的过程中,得以通过人工基因组合成项目进行学习和训练,站在了国际科技前沿。

诺贝尔奖获得者Frances Arnold访问天大合成生物团队
“如果把两篇文章作者在做这个项目时的年龄平均一下的话,应该都到不了二十七八岁。”天大合成生物学团队老师说,这也是他们最在意和最满意之处。用项目做推进,合成生物团队摸索出一种全新的本硕博学生培养路径。
高水平科学研究促进高水平人才培养。大项目给予了新利18网址登录
人才成长和进步的机会和条件,在项目中,教学和新利18网址登录
真正结合起来,大批新利18网址登录
人才通过这种方式得以培养和涌现,跟随项目一起成长。两篇《Science》的第一作者谢泽雄和吴毅就是这样成长起来的,参与该课程时他们还是本科生,边进行“人工基因组设计合成”课程的理论学习,边“真刀真枪”做新利18网址登录
,逐渐具备了较强的实验技能、开阔的国际视野,创新能力也得到了提升。
谢泽雄合成染色体的路上一度陷入困境,他发现合成的V号染色体总是出现“失活”的现象,得到的菌株要么是死的,要么就是长势很弱。经过12个月的反复检测后,还是解决不了“失活“的问题。那还有最后一种可能性——是设计本身出现了问题。果然,他发现以往研究人员在利用计算机进行设计时,缺失了一段基因序列,从而导致染色体“失活”。又经过一年多的攻关,他通过建立多位点基因组精准修复技术,创建了化学合成序列与设计序列完美匹配的V号染色体,解决了染色体精准合成难题,对当前真核生物染色体化学合成的人工设计原则提供了评判标准。 美国哈佛大学基因学教授乔治·丘奇在接受采访中说,谢泽雄的研究成果,堪称“完美”。
负责10号染色体的吴毅发明了一种快速找到染色体缺陷并修复的方法。在美国向国际联盟做分享时,他还觉得“很不好意思”,因为台下的观众是国内外诸多业界“大师”,他们曾是吴毅仰望的偶像,如今在观众席为他鼓掌喝彩。
2016年7月,第五届Sc2.0和合成基因组会议在英国爱丁堡举行,吴毅和谢泽雄介绍了天津大学化学全合成酿酒酵母染色体的最新研究进展。

中国新利18网址登录
工作者从学习经验到贡献智慧,最终赢得了世界的尊重。
进阶:从一项前沿研究到一个前沿学科
合成生物与生物制造是有目的地设计、改造乃至从头合成生物体系,用以解决人类所面临的材料、食品、能源、环境、健康等问题,是生物学、工程学、信息科学、计算机科学、化学和材料学等多学科交叉融合的学科。DNA数字存储,一块方糖大小DNA能存储一百万个硬盘的数据;基因回路设计,能调控免疫系统,疗愈重大疾病;合成基因组,治疗遗传性疾病;定制微生物能降解污染物……据麦肯锡预测,未来全球60%的物质可通过生物合成生产,潜在经济价值达30万亿美元。“合成生物”被列入我国《“十四五”规划和2035年远景目标纲要》,是具有战略性、引领性和颠覆性的未来产业。合成生物学让未来充满无限可能。合成生物学被誉为将引起人类生活以及全球经济发生革命的颠覆性技术,对人类健康、经济与安全产生深远影响。
欧美等发达国家已经将发展合成生物列入国家战略,进行了系统布局。美国成立了若干个研究中心,如MIT和哈佛大学等。英国也成立了十来个合成生物学研究中心。我国在合成生物学方面的研究起步并不算早,但对合成生物学领域的研究相当重视,科技部门也给合成生物学的研究工作和研究者提供了持续的帮助。如果将研究过程用跟跑、并跑、领跑来划分的话,我国做的很多合成生物学的研究工作目前是处于并跑的状态。为了在关键领域占领科技制高点,教育部首批前沿科学中心里合成生物学名列其中,这就是天津大学合成生物学前沿科学中心。揭秘生命起源,抢占生命再造最高峰,孕育引领新经济的颠覆性成果,天津大学被寄予厚望。

从参与一项国际比赛,一门本科课程开始,天津大学从零起步,如今已经走进世界前沿,是我国合成生物学领域的重要创新力量。天津大学在国内最早建立了合成生物学本科专业、硕士和博士学位点,最先编写了合成生物学本科教材《合成生物学导论》。2013年获批合成生物技术国家级国际合作基地,2018年获批教育部“珠峰计划”合成生物学前沿科学中心,2024年获批合成生物技术全国重点实验室,2025年2月28日天津大学决定,成立“天津大学合成生物与生物制造学院”。围绕合成生物学主要研究方向,形成了包括院士、长江、杰青等组成150余人的研究队伍,在基因组设计合成、细胞工厂、DNA数字存储等领域取得了重要突破和一批科技成果。
星光不负赶路人,近年来,天津大学合成生物学进入发展快车道,2019年天津大学成为合成生物学重大设施国际联盟发起单位。2021年天津大学生物安全战略研究中心牵头起草的《生物安全科学家行为准则天津指南》被世卫组织列为全球生物安全道德准则。天津大学合成生物学新利18网址登录
团队汇聚了中国科学院院士、国家杰青、长江特聘教授等一批高水平人才,获得了国家基金委创新研究群体,培养研究生2000人左右。近年来,天大承担了一批合成生物学相关国家重点研发计划项目等国家重大任务,合成生物学研究论文数量逐渐攀升到国际前列。从零到一,经过这些年的加速跑,天津大学的合成生物学研究已经跻身世界第一方阵。

天津大学合成生物学专家作为发言人参加约翰霍普金斯大学主办国际论坛
未来已来等你来
2018年开启了合成生物学研究中基因组重排这一全新研究领域,成果填补了基因组结构变异的技术空白;2019年发现不同尺度人工基因组重排的杂合性缺失现象,为研究大尺度遗传变异提供了强有力的工具;2020年团队首次利用高效乘积编码方法,完成3 MB音视频数据DNA信息存储的全流程验证;2021年研发全球首套DNA数据存储编码系统;2022年一则《DNA存储让敦煌壁画保存千年万年》的消息登上了各大媒体重要版面;2023年突破了电能细胞三维自组装人工导电生物膜的设计构建;2024年创新DNA存储方案破解医疗数据存储难题; 2025年天津大学合成生物技术全国重点实验室发布了真核多重DNA反转系统……天津大学在合成生物学领域成果频传。

基于德布莱英图图论设计的序列重建算法高效解决DNA断裂、降解问题

DNA存储的敦煌壁画
未来已来。畅想合成生物学的未来,元英进教授表示:“我们对合成生物学的探索不仅仅是基因组的合成再造,还发展了人工细胞工厂构筑和DNA信息存储,这些研究进入到了智能化和自动化阶段。DNA信息存储是合成生物学的未来重要方向,是生物技术与信息技术融合的典范。合成生物学将给更多交叉学科带来发展的契机,如应用数学家对DNA进行全新设计编码;化学家设计非天然碱基,从而编码非天然氨基酸的药物;仪器制造专家能够为未来高效的DNA组装和高通量的细胞筛选带来更多的助力。我们相信合成生物学将为人类的生活带来更多的惊喜。”
天津大学合成生物学的大门是敞开的。这里有很多机会,只要“你想”,只要“你能”,就可以成为其中一员。
谢泽雄大三时就进实验室,跟着研究生们做他们的课题,十几年了,他对当时参与的课题仍然能脱口而出:“大三时跟着师兄短期做过VC两菌的适应性进化——生产维生素C的两种菌,后来还做过利用大肠杆菌生产航空燃油的项目。” 这段经历让他受益良多,“本科进实验室让我掌握了实验技能和数据分析能力,培养了严谨的新利18网址登录
思维,为后续发展打下基础。”在实验室中,谢泽雄的身份一直在变,从师弟,到师兄,到谢老师、谢教授,但不变的是,他的身边总有一批热爱新利18网址登录
的学生,“我们组的研究方向是人工基因组设计合成与DNA智能制造技术研究,我们每年都会带本科生,别的组也是如此。”


2024年国际遗传基因工程机器大赛全球总决赛在法国巴黎落下帷幕。当年的学生吴毅,已经成长为吴毅教授,成为参赛团队的指导老师,带领参赛团队获得2块金牌和1项单项奖提名的优秀成绩。参与的学生也不仅仅是化工的学生,生物、计算机、材料,药学……越来越多的学生参与其中。
因为iGEM大赛了解合成生物学的李小倩,后来到加州大学洛杉矶分校继续合成生物学博士课题的相关研究,目前她是硅谷一家律师事务所的专利代理人。“我见证了合成生物学在不同领域,特别是在一些交叉学科领域的技术成果中发挥了越来越重大的作用。近些年来,天津大学在合成生物学领域里面捷报频传,让我十分骄傲。”
合成生物学专业2017年开始招收本科生,2021年被评为国家一流专业,2025年列入教育部“强基计划”。“天津大学这些年合成生物学发展的最大成果其实是培养了人才,为中国乃至世界的合成生物学发展贡献了大量高端人才,积蓄了创造未来的力量。”元英进说。
(编辑 赵晖 刘延俊 李研 郭新婷 图片提供 校电视台)